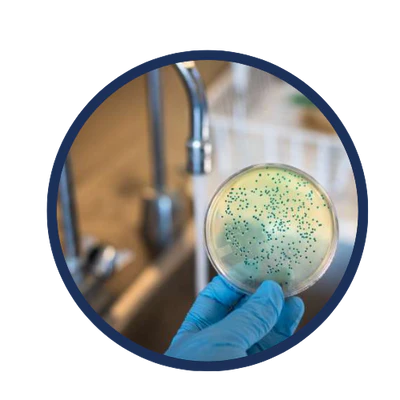

AquaLife срещу обикновените решения
По-добро здраве
По-добър вкус и аромат
По-малко разходи за бутилирана вода
По-добра грижа за кожата и косата
АкваЛайф
Филтър за под мивка
Филтърни кани за вода
Пречиствания 99% от водата
Екологичен и икономичен
Филтрира бактерии, вируси и пестициди
Ултраефективна филтрация (0,2 микрона)
Евтин вариант в дългосрочен план
Лесно и просто монтиране
„Наистина лесен за монтаж и отлично качество“ - Йордан Й.

С 5в1 воден филтър на AquaLife
- Филтриране на над 100+ замърсителя
- По-здрава кожа и повишена енергия
- По-чиста и вкусна вода
- Значителни дългосрочни спестявания
- Намалена вероятност от заболяване/болест

Без филтър за чешмяна вода AquaLife
- 100+ замърсителя/примеси във водата
- Добавен хлор, флуорид, тежки метали
- Високо съдържание на пластмасови отпадъци от бутилирана вода
- По-висок риск от заболяване и дехидратация
- Основна/остаряла или липсваща система за филтриране